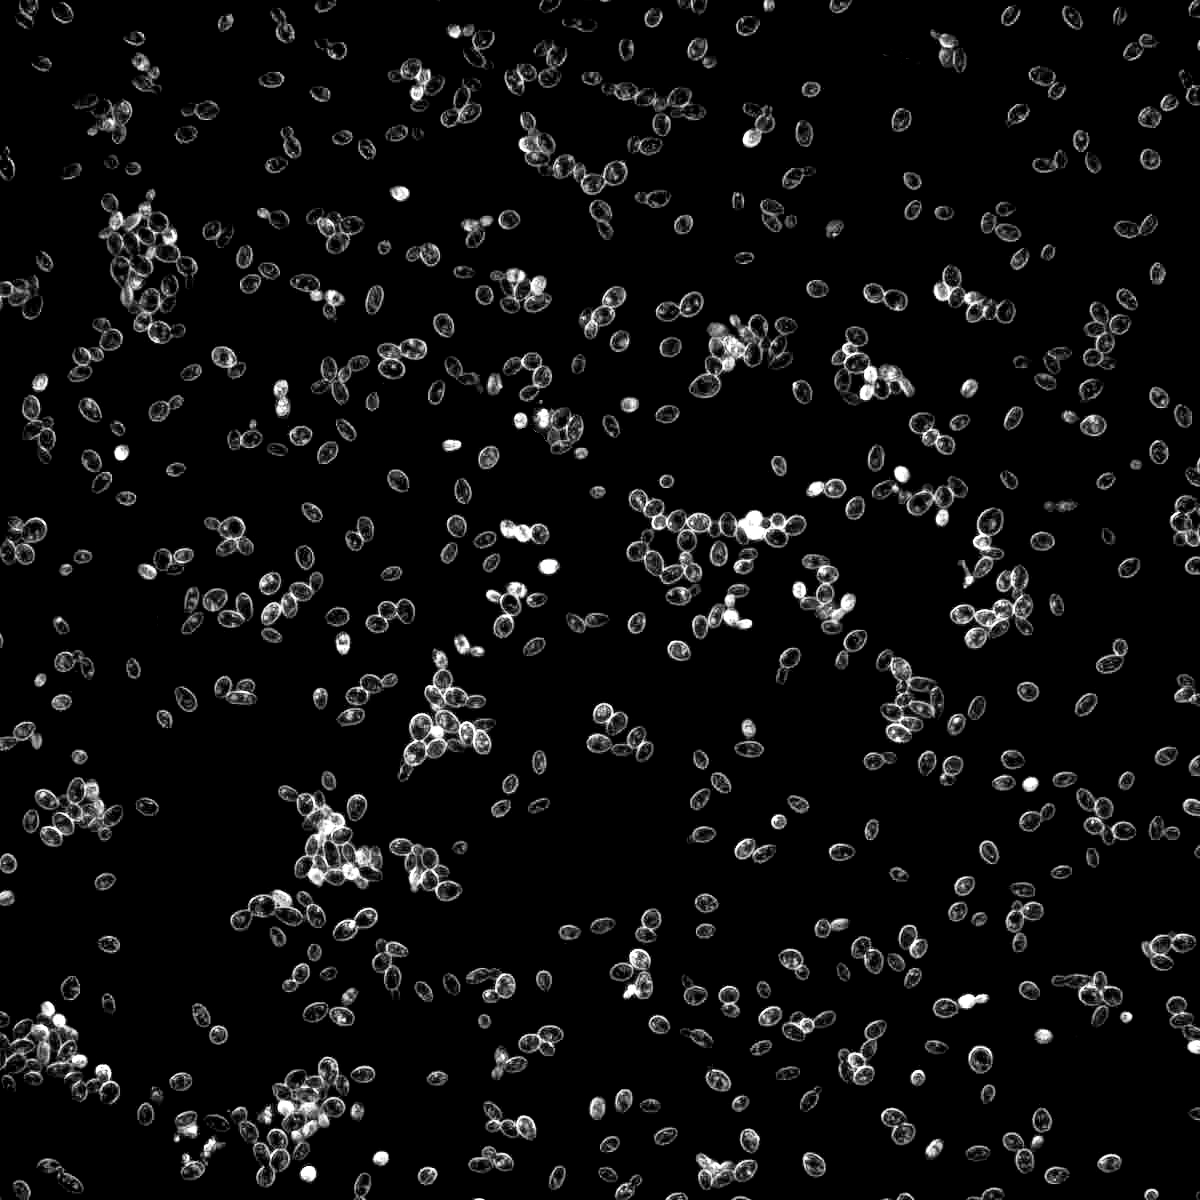
1388

Strain: 1388
Belgian Strong Ale
Species: Saccharomyces cerevisiae var. diastaticus
Profile: The classic choice for brewing golden strong ales. This alcohol tolerant strain will produce a complex ester profile balanced nicely with subtle phenolics. Malt flavors and aromas will remain even with a well attenuated dry, tart finish. This strain is prone to stalling at approximately 1.035; racking or slight aeration will encourage it to finish fermentation. This Wyeast yeast strain has been classified as Saccharomyces cerevisiae var. diastaticus using rapid PCR analysis. This strain carries the STA1 gene, which is the “signature” gene of Saccharomyces cerevisiae var. diastaticus and will be found in all diastaticus strains.
Used in:
-
Flocculation
Low -
Apparent Attenuation
74 - 78% -
Apparent ABV Tolerance
12 - 13% -
Temperature Range
64-80°F (18-27°C)